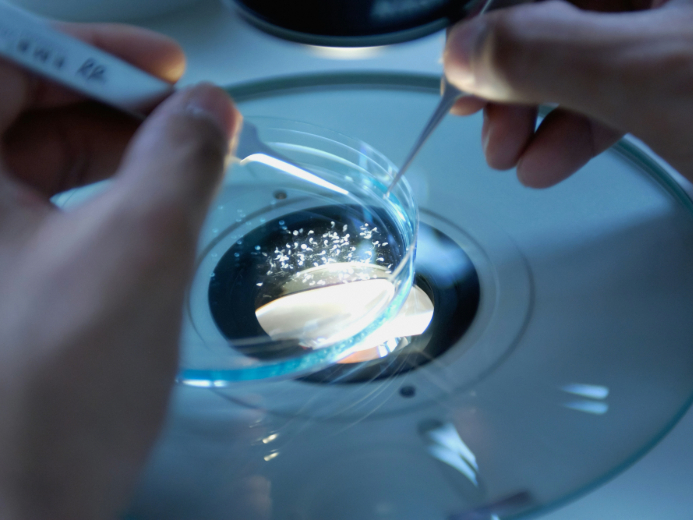
MTRI_693x520

Knowledge Transfer
Material Science and Materials Technology Impact Case


Start-up Companies
Within our Department, we have successfully established 6 startups led by both academic and student innovators. These ventures serve as platforms to translate our research excellence into practical applications that make a meaningful impact.
For detailed information on the startup companies associated with the Department of Applied Physics, please click the link below:
PolyU Mainland Translational Research Institutes

Collaborative Research
By collaborating with industry partners, we open up valuable opportunities to address future needs through the adoption of our cutting-edge research and innovations. Besides, consultancy services are available. Please see the Expert Directory to reach our experts.
Funded Projects

Commercialization and Patents
AP has invented a variety of patent-protected technologies to assist in strengthening business competitiveness. Details of PolyU’s patents can also be accessed through our Patent Search Engines.
Internship Opportunities






